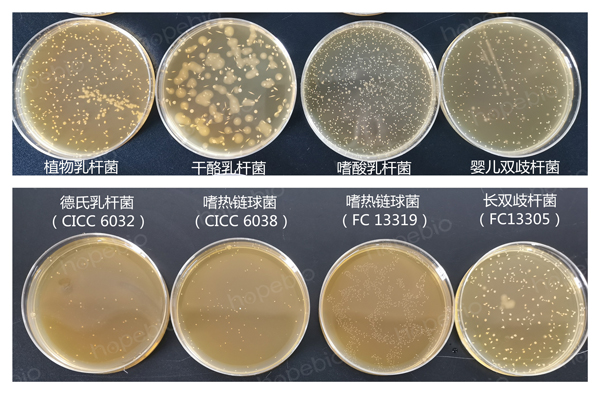
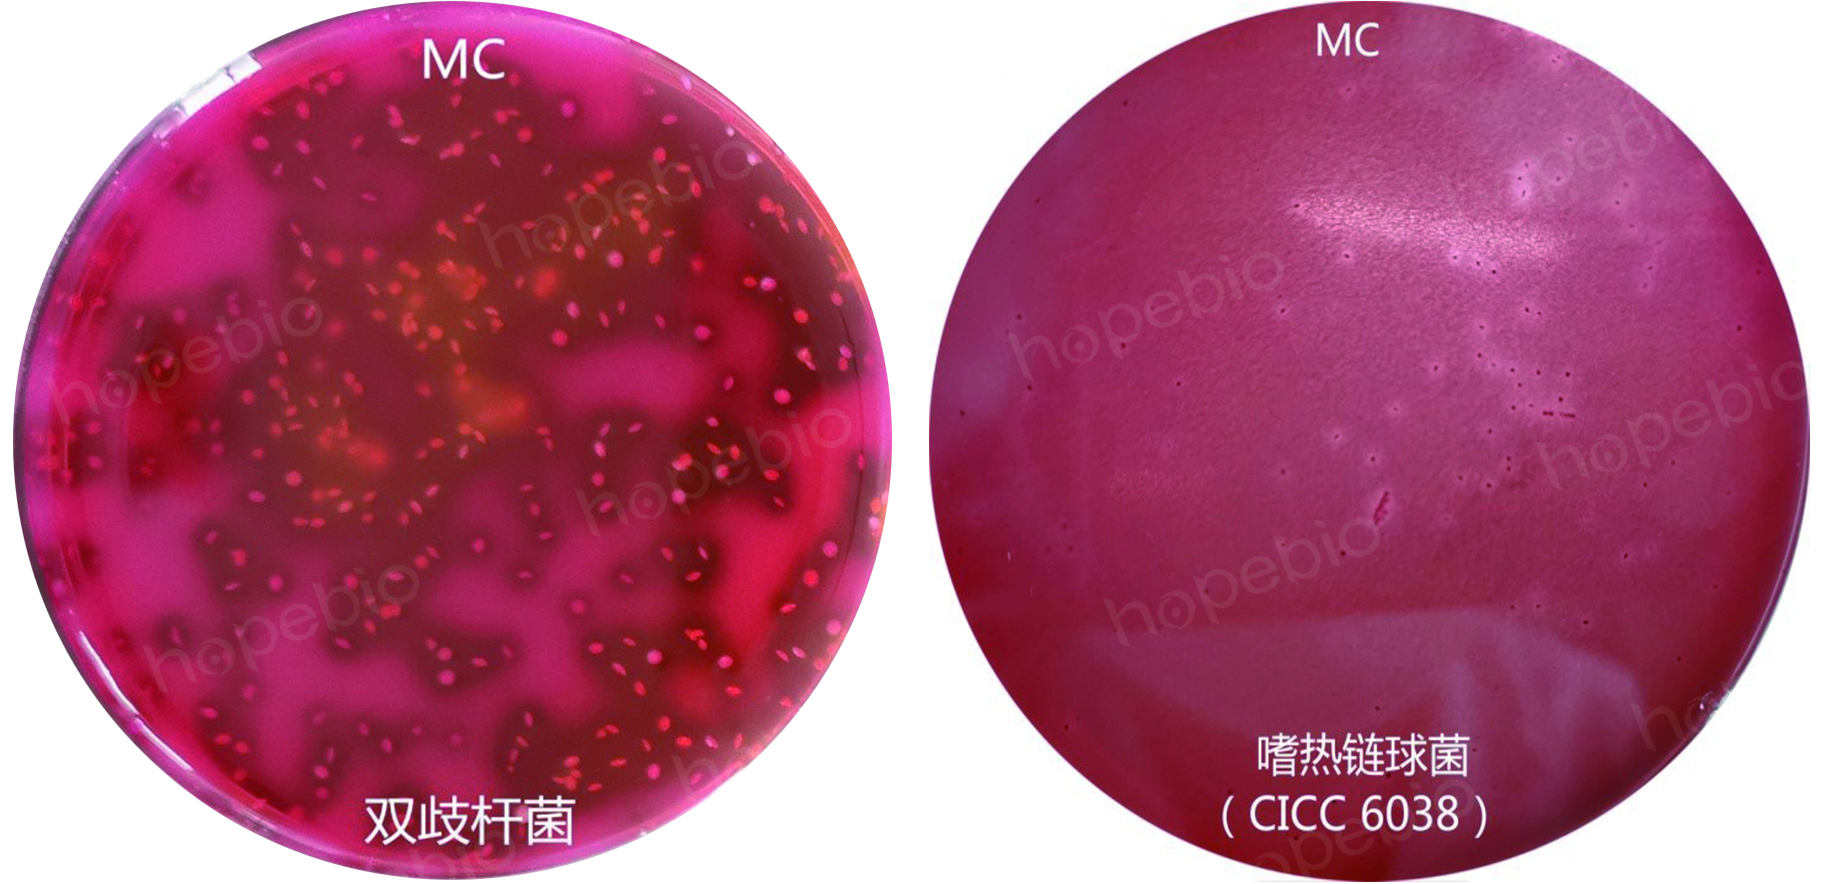
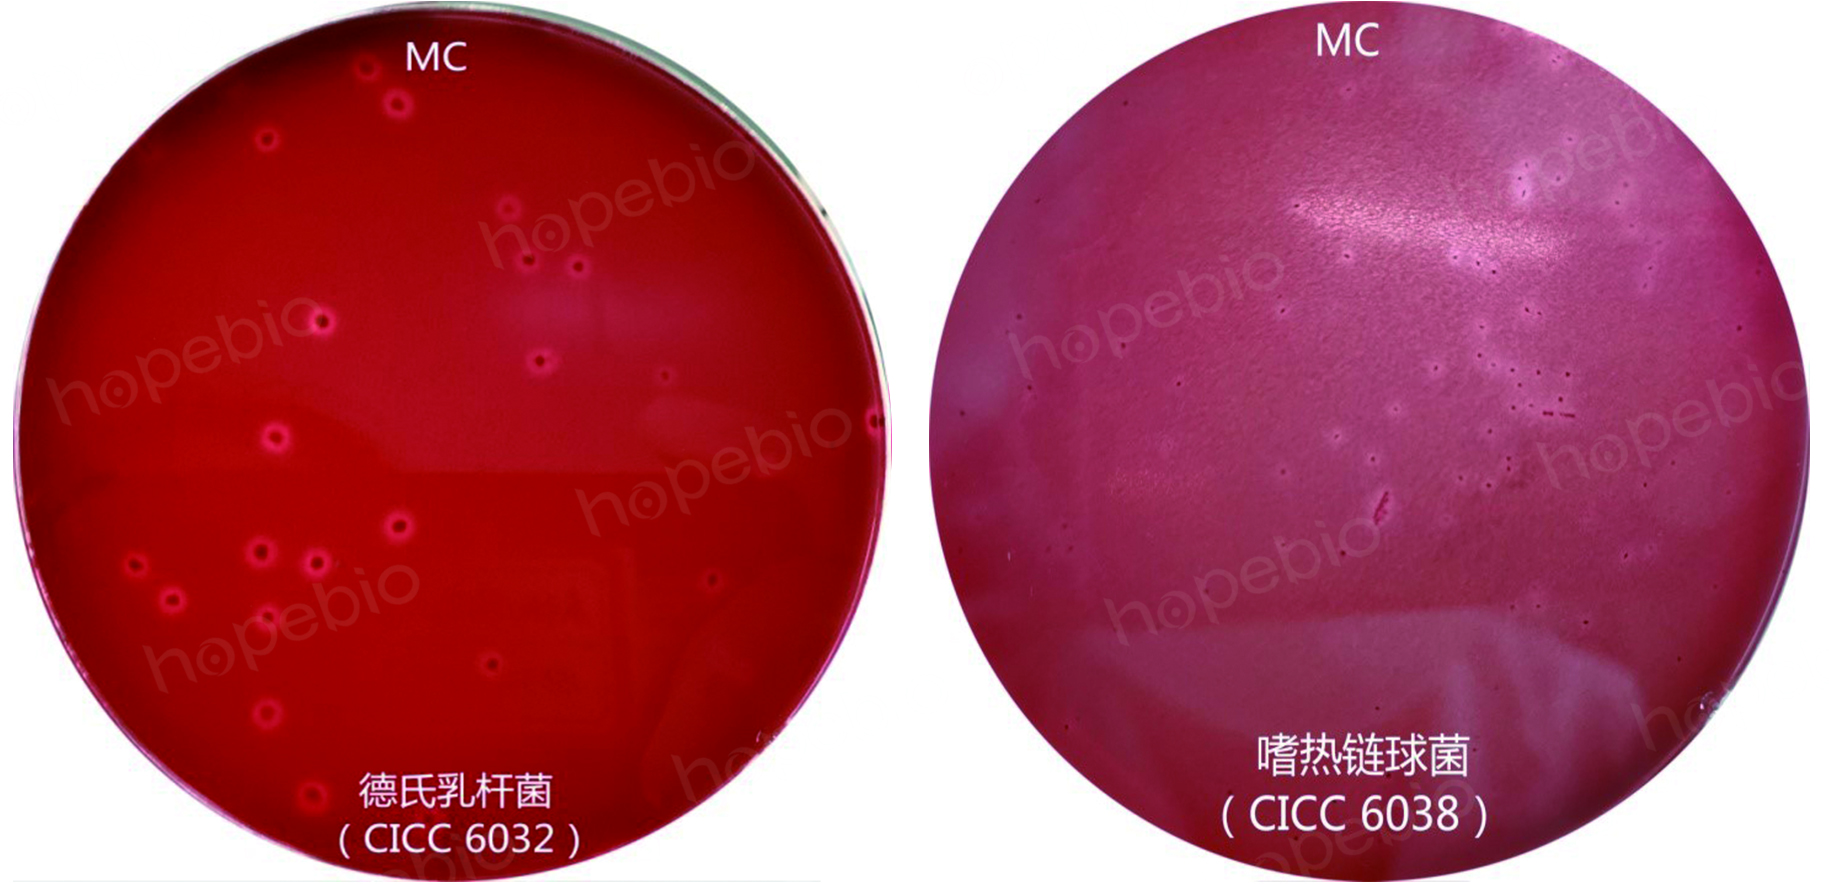

海博微信公众号
海博微信公众号
 海博天猫旗舰店
海博天猫旗舰店


 海博微信公众号
海博微信公众号
 海博天猫旗舰店
海博天猫旗舰店




一、 引言
前期曾介绍了乳酸菌的分类和乳酸菌检验所用的几种主要培养基,本文将进一步就GB 4789.35中乳酸菌检验时所用的计数方法和规则进行详细解读。
二、计数方法
《GB 4789.35 食品安全国家标准 食品微生物学检验 乳酸菌检验》中,主要涉及了3种乳酸菌,分别为乳杆菌属、双歧杆菌属和嗜热链球菌属。由于3种乳酸菌的培养条件和特征各有不同,要检验出样品中乳酸菌的总数,就需要根据菌种的不同选择使用合适的培养基,对结果进行计数。标准中是这样规定的:(表1)

其中:
6.2.3.2 是使用改良MRS培养基倾注,厌氧培养,对双歧杆菌进行计数;
6.2.3.3 是使用MC培养基倾注,需氧培养,对嗜热链球菌进行计数;
6.2.3.4 是使用MRS培养基倾注,厌氧培养,对乳杆菌(或乳杆菌与双歧杆菌)进行计数。
从表中可以看出,在检验乳酸菌数量时,是分了3种情况分别进行规定:
1、单一菌种的情况
(1)只有双歧杆菌时,使用MRS培养基或者双歧杆菌琼脂倾注、培养、计数;
(2)只有乳杆菌时,使用MRS培养基进行培养计数;
(3)只有嗜热链球菌时,使用MC培养基进行培养计数。此处需要说明一下,嗜热链球菌在MRS上也能生长良好(如图1),所以当只有这种单一菌种存在时,日常工作中,如果不需要完全按照国标要求,是否可以使用MRS培养基进行培养计数?
图1 MRS上三种菌的生长情况
综合比较,当只有单一菌种存在的情况下,如果不需要严格按照国标要求来操作,只需要将样品稀释后,取合适浓度用MRS培养基进行倾注计数即可。MRS可以作为通用培养基使用。
2、两种菌的情况
如果样品中有两种菌存在,除了要检验出乳酸菌的总数外,有时还需要对其中各个菌种的数目进行统计。
(1)含有双歧杆菌和乳杆菌时,使用MRS培养基对样品进行倾注后厌氧培养,即可得出两种乳酸菌的总数;而如果还想知道里面所含双歧杆菌的数目,则需要同时用改良MRS进行倾注计数,改良MRS上长出的菌落数,即为双歧杆菌的数目。
(2)含有双歧杆菌和嗜热链球菌时,标准中使用改良MRS和MC进行倾注计数,分别得出双歧杆菌和嗜热链球菌的数目,两者加在一起即为菌落总数。采用改良MRS对双歧杆菌进行计数,这个没有争议,因为在改良MRS琼脂中,只有双歧杆菌能生长,嗜热链球菌不能生长。
在MC琼脂上,虽然在厌氧条件下,嗜热链球菌和双歧杆菌都能生长(如图2),但本标准中要求需氧培养,所以此时MC琼脂上长出的就只有嗜热链球菌了。这个方法是可以达到计数嗜热链球菌的目的的。
图2 厌氧培养条件下MC琼脂上双歧杆菌和嗜热链球菌的生长状态
在日常工作中,如果不严格按照国标要求,我们也可以选择使用MRS琼脂和改良MRS琼脂进行倾注培养,MRS平板上所有菌落之和即为菌落总数,改良MRS平板上的菌数即为双歧杆菌的菌数。
(3)含有乳杆菌和嗜热链球菌时,标准中采用MRS琼脂厌氧培养和MC琼脂需氧培养进行计数,分别得出乳杆菌和嗜热链球菌的数目,两者之和算作乳酸菌的总数。
这一规定的问题在于:因为这两种菌都能在这两种培养基上生长良好,即MRS琼脂上可以长出乳杆菌和嗜热链球菌(嗜热链球菌在MRS培养基上厌氧培养的结果,如图3),MC琼脂上也能长出乳杆菌和嗜热链球菌,只是菌落大小的差异。其中在MRS琼脂上,虽然多数乳杆菌菌落较大,但对于有些乳杆菌(如德氏乳杆菌CICC 6032),菌落直径也很小,跟嗜热链球菌很容易混淆(如图3)。

图3 MRS上德氏乳杆菌和嗜热链球菌的菌落形态
同样,两种菌在MC琼脂上的菌落形态如下图(图4):
图4 德氏乳杆菌和嗜热链球菌在MC培养基上的菌落形态
所以,要想从同一种培养基上,明显地区分出两种菌来,分别计数,确实也不容易。
问题的关键在于,标准中明确规定,将两种培养基上培养出的菌数,进行相加,即得乳酸菌总数。通过上面的分析,我们不难得出,这样处理,得出的结果实际上是把乳酸菌总数翻倍了,即乳杆菌和嗜热链球菌的数目分别重复了两遍,并且也不能明确得出每种乳酸菌的具体数目。
综合以上三种情况,我们可以总结为,在不需要严格按照标准操作的前提下,如果已知样品中有两种乳酸菌,要检验样品中的乳酸菌总数,只要用MRS进行倾注就可以了,平板上长出的菌数即为乳酸菌总数;而要确切地知道其中某一种菌的数目,则要根据情况进行培养基的选择:使用改良MRS可以很容易得出双歧杆菌的数目,使用MC可以勉强计出嗜热链球菌的数目,但要注意避免其他菌种的干扰;对于乳杆菌的数目,只要用菌落总数减去已经计出的另一种菌的数目即可。
3、三种菌的情况
标准中规定,用MC需氧培养,得出嗜热链球菌的数目;MRS厌氧培养,得出乳酸菌和双歧杆菌的总数,最后将两者加和,即为乳酸菌总数;如果要单独检验双歧杆菌的数目,则采用改良MRS琼脂进行厌氧培养后计数可得。
这里同样存在上面所述的问题。
对于标准中为什么这么写,我们可以理解成,它默认了在MRS琼脂上嗜热链球菌不会生长,而在MC琼脂上乳杆菌不会生长?但这明显是与我们实际操作情况不相符的。
如果按照这种要求进行计数,最终所得的数目,将会把乳杆菌和嗜热链球菌重复计数。
在日常工作中,如果不需要严格按照国标操作,要解决这一问题,我们还是借助这两种培养基,只要将MRS上长出的所有菌落数出来,即为样品中的菌落总数。而如果非要追究里面所含嗜热链球菌的数目,只能借助MC琼脂,计数时要仔细甄别,不要误将乳杆菌计成了嗜热链球菌,从而导致结果误差;最后用菌落总数减去嗜热链球菌的数目,即为乳杆菌的数目。
这样一来,我们可以将上面三种情况进行总结,如下表:
表2 乳酸菌计数时培养基的选择及计数方法表
|
参考方式 |
菌种 |
总数 |
单独计数 |
||
|
双歧杆菌 |
嗜热链球菌 |
乳杆菌 |
|||
|
GB规定 |
1种 |
/ |
MRS/双歧杆菌琼脂 |
MC |
MRS |
|
2种 |
MRS |
改良MRS |
/ |
√ |
|
|
改良MRS+MC |
改良MRS |
MC |
/ |
||
|
MRS+MC |
/ |
MC |
MRS |
||
|
3种 |
MRS+MC |
改良MRS |
MC |
/ |
|
|
日常选择 |
1种 |
MRS |
/ |
/ |
/ |
|
2种 |
MRS |
改良MRS |
计算/MC |
计算 |
|
|
3种 |
MRS |
改良MRS |
MC |
计算 |
|
注:表格中所有使用MC琼脂的,均采用需氧培养方式;其它培养基均为厌氧培养
通过表格,我们可以一目了然地对乳酸菌计数中使用的培养基进行选择:在不需严格按照国标要求进行操作的情况下,不管样品中含有几种菌,只要求总数,统一用MRS琼脂即可,MRS琼脂可以算得上检验乳酸菌菌落总数的“王牌培养基”;在多种菌种共存的情况下,要想知道双歧杆菌的数目,直接选择改良MRS;对于嗜热链球菌可以通过计算或MC倾注的方式得到,本人建议能计算的情况下,首选计算方法;而对于乳杆菌的数目,只能采用计算的方法得到,因为GB中并没有一种特定的培养基,能将乳杆菌与其它种类的乳酸菌区分开来。
三、计数规则
上面讨论的三种乳酸菌的培养计数方法,当选用了合适的方法,培养出菌落后,怎么选择合适的平板进行计数,也是实验人员要面临的问题。
对于这一点,标准中逐条做出了规定,为了方便大家理解和掌握,笔者特整合成下面的图示进行说明(图5),希望能给广大实验人员提供帮助。

图5 菌落计数规则
四、说明
在样品(包括食品、药品、化妆品等)检验过程中,检验人员应首先参考相应的标准进行各项操作,只要标准没有错误,就应该严格按照标准规定的条件和方法来检验,这样才能保证检验结果的一致性和可靠性。但是,如果标准中的个别地方出现了明显的疑义或者有些方法不利于正确结果的判断,究竟该怎么处理,要具体情况具体分析。
相关文章:
相关产品:
相关标准:
注:本文属海博生物原创,未经允许不得转载。



